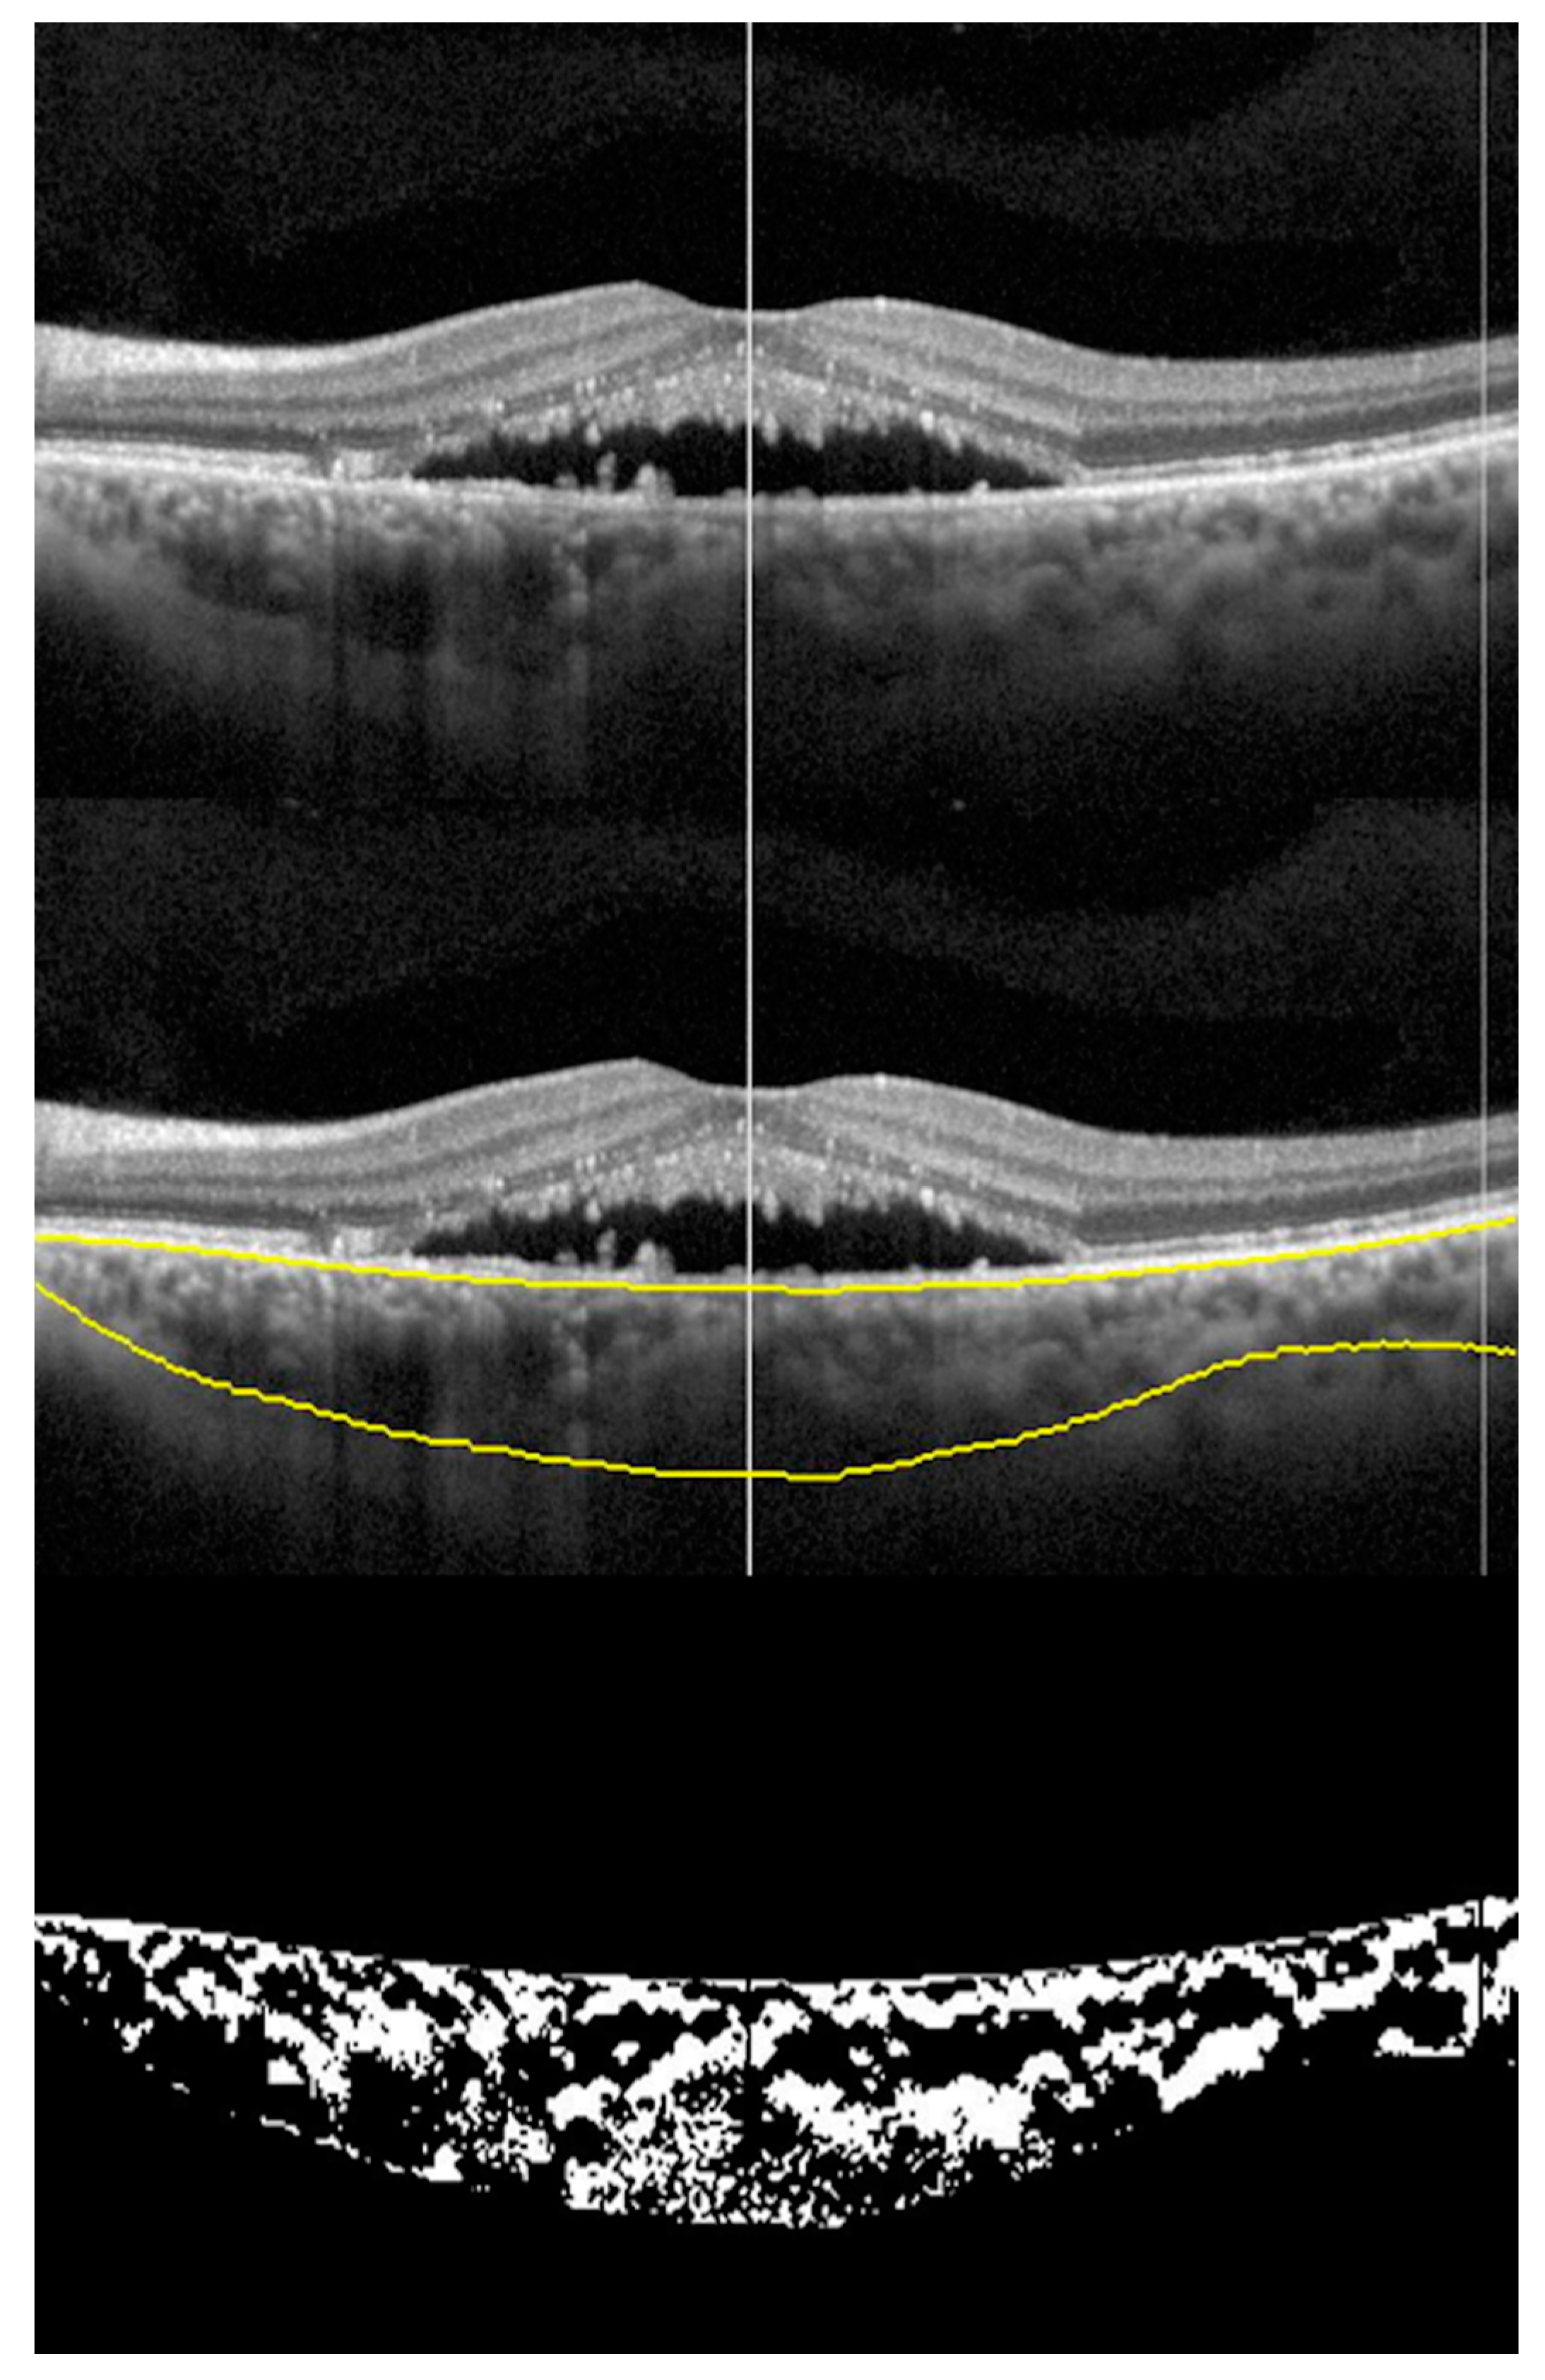
Vision 04 00044 g002 Vision 04 00044 g002

Current Choroidal Imaging Findings in Central Serous Chorioretinopathy
Abstract
1. Introduction
2. Methods
3. Results/Findings
3.1. Choroidal Layer Thickness in CSCR
3.2. Choroidal Vascularity Index (CVI) in CSCR
Choroidal Vascularity Changes in Acute CSCR
3.3. Wide Field Choroidal Vascularity and Choroidal Thickness in Healthy and CSCR
3.4. En Face Enhanced-Depth Swept Source-Optical Coherence Tomography Features in CSCR
En Face Choroidal Vascularity in CSCR
3.5. Choroidal Vascular Reactivity in CSCR
3.6. Choriocapillaris on OCT and OCTA in CSCR
3.7. Retinal and Choroidal Hyper-Reflective Dots (HRDs) in CSCR
3.8. Haller Vessel Segmentation
4. Future Research Directions and Limitations
5. Conclusions
Author Contributions
Funding
Conflicts of Interest
References
- Liegl, R.; Ulbig, M.W. Central serous chorioretinopathy. Ophthalmologica 2014, 232, 65–76. [Google Scholar] [CrossRef] [PubMed]
- Mudvari, S.S.; Goff, M.J.; Fu, A.D.; McDonald, H.R.; Johnson, R.N.; Ai, E.; Jumper, J.M. The natural history of pigment epithelial detachment associated with central serous chorioretinopathy. Retina 2007, 27, 1168–1173. [Google Scholar] [CrossRef] [PubMed]
- Baran, N.V.; Gurlu, V.P.; Esgin, H. Long-term macular function in eyes with central serous chorioretinopathy. Clin. Exp. Ophthalmol. 2005, 33, 369–372. [Google Scholar] [CrossRef] [PubMed]
- Sartini, F.; Menchini, M.; Posarelli, C.; Casini, G.; Figus, M. Bullous Central Serous Chorioretinopathy: A Rare and Atypical Form of Central Serous Chorioretinopathy. A Systematic Review. Pharmaceuticals 2020, 13, 221. [Google Scholar] [CrossRef] [PubMed]
- Plateroti, A.M.; Witmer, M.T.; Kiss, S.; D’Amico, N.J. Characteristics of intraretinal deposits in acute central serous chorioretinopathy. Clin. Ophthalmol. 2014, 8, 673–676. [Google Scholar] [CrossRef] [PubMed]
- Daruich, A.; Matet, A.; Dirani, A.; Bousquet, E.; Zhao, M.; Farman, N.; Jaisser, F.; Behar-Cohen, F. Central serous chorioretinopathy: Recent findings and new physiopathology hypothesis. Prog. Retin. Eye Res. 2015, 48, 82–118. [Google Scholar] [CrossRef]
- Khairallah, M.; Kahloun, R.; Tugal-Tutkun, I. Central serous chorioretinopathy, corticosteroids, and uveitis. Ocul. Immunol. Inflamm. 2012, 20, 76–85. [Google Scholar] [CrossRef]
- Haimovici, R.; Koh, S.; Gagnon, D.R.; Lehrfeld, T.; Wellik, S. Central Serous Chorioretinopathy Case-Control Study G. Risk factors for central serous chorioretinopathy: A case-control study. Ophthalmology 2004, 111, 244–249. [Google Scholar] [CrossRef]
- Lehmann, M.; Bousquet, E.; Beydoun, T.; Behar-Cohen, F. PACHYCHOROID: An inherited condition? Retina 2015, 35, 10–16. [Google Scholar] [CrossRef]
- Gomez-Sanchez, E.; Gomez-Sanchez, C.E. The multifaceted mineralocorticoid receptor. Compr. Physiol. 2014, 4, 965–994. [Google Scholar]
- Zhao, M.; Célérier, I.; Bousquet, E.; Jeanny, J.-C.; Jonet, L.; Savoldelli, M.; Offret, O.; Curan, A.; Farman, N.; Jaisser, F.; et al. Mineralocorticoid receptor is involved in rat and human ocular chorioretinopathy. J. Clin. Investig. 2012, 122, 2672–2679. [Google Scholar] [CrossRef] [PubMed]
- Chung, Y.R.; Kim, J.W.; Kim, S.W.; Lee, K. Choroidal thickness in patients with central serous chorioretinopathy: Assessment of Haller and Sattler Layers. Retina 2016, 36, 1652–1657. [Google Scholar] [CrossRef] [PubMed]
- Agrawal, R.; Chhablani, J.; Tan, K.A.; Shah, S.; Sarvaiya, C.; Banker, A. Choroidal Vascularity Index in Central Serous Chorioretinopathy. Retina 2016, 36, 1646–1651. [Google Scholar] [CrossRef] [PubMed]
- Toto, L.; D’Aloisio, R.; Mastropasqua, R.; Di Antonio, L.; Di Nicola, M.; Di Martino, G.; Evangelista, F.; Erroi, E.; Doronzo, E.; Mariotti, C. Anatomical and Functional Changes of the Retina and the Choroid after Resolved Chronic CSCR. J. Clin. Med. 2019, 8, 474. [Google Scholar] [CrossRef]
- Manayath, G.J.; Ranjan, R.; Shah, V.S.; Karandikar, S.S.; Saravanan, V.R.; Narendran, V. Central serous chorioretinopathy: Current update on pathophysiology and multimodal imaging. Oman J. Ophthalmol. 2018, 11, 103–112. [Google Scholar]
- Bujarborua, D.; Nagpal, P.N.; Deka, M. Smokestack leak in central serous chorioretinopathy. Graefes Arch. Clin. Exp. Ophthalmol. 2010, 248, 339–351. [Google Scholar] [CrossRef]
- Shahin, M.M. Angiographic characteristics of central serous chorioretinopathy in an Egyptian population. Int. J. Ophthalmol. 2013, 6, 342–345. [Google Scholar]
- Ayata, A.; Tatlipinar, S.; Kar, T.; Unal, M.; Ersanli, D.; Bilge, A.H. Near-infrared and short-wavelength autofluorescence imaging in central serous chorioretinopathy. Br. J. Ophthalmol. 2009, 93, 79–82. [Google Scholar] [CrossRef]
- Sekiryu, T.; Iida, T.; Maruko, I.; Saito, K.; Kondo, T. Infrared fundus autofluorescence and central serous chorioretinopathy. Investig. Ophthalmol. Vis. Sci. 2010, 51, 4956–4962. [Google Scholar] [CrossRef]
- Hirami, Y.; Tsujikawa, A.; Sasahara, M.; Gotoh, N.; Tamura, H.; Otani, A.; Mandai, M.; Yoshimura, N. Alterations of retinal pigment epithelium in central serous chorioretinopathy. Clin. Exp. Ophthalmol. 2007, 35, 225–230. [Google Scholar] [CrossRef]
- Flower, R.; Peiretti, E.; Magnani, M.; Rossi, L.; Serafini, S.; Gryczynski, Z.; Gryczynski, I. Observation of Erythrocyte Dynamics in the Retinal Capillaries and Choriocapillaris Using ICG-Loaded Erythrocyte Ghost Cells. Investig. Opthalmol. Vis. Sci. 2008, 49, 5510–5516. [Google Scholar] [CrossRef]
- Yannuzzi, L.A.; Shakin, J.L.; Fisher, Y.L.; Altomonte, M.A. Peripheral retinal detachments and retinal pigment epithelial atrophic tracts secondary to central serous pigment epitheliopathy. 1984. Retina 2012, 32, 1554–1572. [Google Scholar] [CrossRef]
- Ferguson, R.D.; Zhong, Z.; Hammer, D.X.; Mujat, M.; Patel, A.H.; Deng, C.; Zou, W.; Burns, S.A. Adaptive optics scanning laser ophthalmoscope with integrated wide-field retinal imaging and tracking. J. Opt. Soc. Am. A Opt. Image Sci. Vis. 2010, 27, A265–A277. [Google Scholar] [CrossRef] [PubMed]
- Merino, D.; Loza-Alvarez, P. Adaptive optics scanning laser ophthalmoscope imaging: Technology update. Clin. Ophthalmol. 2016, 10, 743–755. [Google Scholar] [CrossRef]
- Romero-Borja, F.; Venkateswaran, K.; Roorda, A.; Hebert, T. Optical slicing of human retinal tissue in vivo with the adaptive optics scanning laser ophthalmoscope. Appl. Opt. 2005, 44, 4032–4040. [Google Scholar] [CrossRef] [PubMed]
- Chen, M.F.; Chui, T.Y.; Alhadeff, P.; Rosen, R.B.; Ritch, R.; Dubra, A.; Hood, N.C. Adaptive Optics Imaging of Healthy and Abnormal Regions of Retinal Nerve Fiber Bundles of Patients With Glaucoma. Investig. Opthalmol. Vis. Sci. 2015, 56, 674–681. [Google Scholar] [CrossRef] [PubMed]
- Zhang, Y.; Wang, X.; Rivero, E.B.; Clark, M.E.; Witherspoon, C.D.; Spaide, R.F.; Girkin, C.A.; Owsley, C.; Curcio, C.A. Photoreceptor Perturbation Around Subretinal Drusenoid Deposits as Revealed by Adaptive Optics Scanning Laser Ophthalmoscopy. Am. J. Ophthalmol. 2014, 158, 584–596.e581. [Google Scholar] [CrossRef]
- Zayit-Soudry, S.; Duncan, J.L.; Syed, R.; Menghini, M.; Roorda, A.J. Cone structure imaged with adaptive optics scanning laser ophthalmoscopy in eyes with nonneovascular age-related macular degeneration. Investig. Ophthalmol. Vis. Sci. 2013, 54, 7498–7509. [Google Scholar] [CrossRef]
- Meadway, A.; Wang, X.; Curcio, C.A.; Zhang, Y. Microstructure of subretinal drusenoid deposits revealed by adaptive optics imaging. Biomed. Opt. Express 2014, 5, 713–727. [Google Scholar] [CrossRef]
- Roorda, A.; Romero-Borja, F.; Iii, W.D.; Queener, H.; Hebert, T.; Campbell, M. Adaptive optics scanning laser ophthalmoscopy. Opt. Express 2002, 10, 405–412. [Google Scholar] [CrossRef]
- Meirelles, A.L.B.; Rodrigues, M.W.; Guirado, A.F.; Jorge, R. Photoreceptor assessment using adaptive optics in resolved central serous chorioretinopathy. Arq. Bras. Oftalmol. 2017, 80, 192–195. [Google Scholar] [CrossRef]
- Ochinciuc, R.; Ochinciuc, U.; Stanca, H.T.; Barac, R.; Darabus, D.; Şuţă, M.; Baltă, F.; Burcea, M. Photoreceptor assessment in focal laser-treated central serous chorioretinopathy using adaptive optics and fundus autofluorescence. Medicine 2020, 99, e19536. [Google Scholar] [CrossRef]
- Ooto, S.; Hangai, M.; Sakamoto, A.; Tsujikawa, A.; Yamashiro, K.; Ojima, Y.; Yamada, Y.; Mukai, H.; Oshima, S.; Inoue, T.; et al. High-Resolution Imaging of Resolved Central Serous Chorioretinopathy Using Adaptive Optics Scanning Laser Ophthalmoscopy. Ophthalmologzy 2010, 117, 1800–1809. [Google Scholar] [CrossRef]
- Vogel, R.N.; Langlo, C.S.; Scoles, D.; Carroll, J.; Weinberg, D.V.; Kim, J.E. High-Resolution Imaging of Intraretinal Structures in Active and Resolved Central Serous Chorioretinopathy. Investig. Ophthalmol. Vis. Sci. 2017, 58, 42–49. [Google Scholar] [CrossRef]
- Iacono, P.; Battaglia, P.M.; Papayannis, A.; La Spina, C.; Varano, M.; Bandello, F. Acute central serous chorioretinopathy: A correlation study between fundus autofluorescence and spectral-domain OCT. Graefes Arch. Clin. Exp. Ophthalmol. 2015, 253, 1889–1897. [Google Scholar] [CrossRef]
- Iovino, C.; Pellegrini, M.; Bernabei, F.; Borrelli, E.; Sacconi, R.; Govetto, A.; Vagge, A.; Di Di Zazzo, A.; Forlini, M.; Finocchio, L.; et al. Choroidal Vascularity Index: An In-Depth Analysis of This Novel Optical Coherence Tomography Parameter. J. Clin. Med. 2020, 9, 595. [Google Scholar] [CrossRef]
- Kowalczuk, L.; Matet, A.; Dor, M.; Bararpour, N.; Daruich, A.; Dirani, A.; Behar-Cohen, F.; Thomas, A.; Turck, N. Proteome and Metabolome of Subretinal Fluid in Central Serous Chorioretinopathy and Rhegmatogenous Retinal Detachment: A Pilot Case Study. Transl. Vis. Sci. Technol. 2018, 7, 3. [Google Scholar] [CrossRef]
- Regatieri, C.V.; Novais, E.A.; Branchini, L.; Adhi, M.; Cole, E.D.; Louzada, R.N.; Lane, M.; Reichel, E.; Duker, J.S. Choroidal thickness in older patients with central serous chorioretinopathy. Int. J. Retina Vitr. 2016, 2, 22. [Google Scholar] [CrossRef] [PubMed]
- Kuroda, S.; Ikuno, Y.; Yasuno, Y.; Nakai, K.; Usui, S.; Sawa, M.; Tsujikawa, M.; Gomi, F.; Nishida, K. Choroidal thickness in central serous chorioretinopathy. Retina 2013, 33, 302–308. [Google Scholar] [CrossRef] [PubMed]
- Goktas, A. Correlation of subretinal fluid volume with choroidal thickness and macular volume in acute central serous chorioretinopathy. Eye 2014, 28, 1431–1436. [Google Scholar] [CrossRef] [PubMed]
- Van Rijssen, T.J.; Van Dijk, E.H.C.; Scholz, P.; Breukink, M.B.; Blanco-Garavito, R.; Souied, E.H.; MacLaren, R.E.; Querques, G.; Fauser, S.; Hoyng, C.B.; et al. Patient characteristics of untreated chronic central serous chorioretinopathy patients with focal versus diffuse leakage. Graefes Arch. Clin. Exp. Ophthalmol. 2019, 257, 1419–1425. [Google Scholar] [CrossRef]
- Bussel, I.I.; Lally, D.R.; Waheed, N.K. Bilateral central serous chorioretinopathy associated with estrogen modulator diindolylmethane. Ophthalmic Surg. Lasers Imaging Retin. 2014, 45, 589–591. [Google Scholar] [CrossRef] [PubMed]
- Chakraborti, C.; Samanta, S.K.; Faiduddin, K.; Choudhury, K.P.; Kumar, S.; Mondal, R. Bilateral central serous chorio-retinopathy in pregnancy presenting with severe visual loss. Nepal J. Ophthalmol. 2014, 6, 220–223. [Google Scholar] [CrossRef] [PubMed]
- Chhablani, J.; Hanumunthadu, D.; Van Dijk, E.H.C.; Dumpala, S.; Rajesh, B.; Jabeen, A.; Jabeen, A.; Ansari, M.; Mehta, P.; Shah, S.; et al. Evaluation of choroidal layer thickness in central serous chorioretinopathy. J. Ophthalmic Vis. Res. 2019, 14, 164–170. [Google Scholar] [CrossRef] [PubMed]
- Chung, Y.R.; Kim, J.W.; Choi, S.Y.; Park, S.W.; Kim, J.H.; Lee, K. Subfoveal Choroidal Thickness and Vascular Diameter in Active and Resolved Central Serous Chorioretinopathy. Retina 2018, 38, 102–107. [Google Scholar] [CrossRef]
- Yannuzzi, L.A. Central serous chorioretinopathy: A personal perspective. Am. J. Ophthalmol. 2010, 149, 361–363. [Google Scholar] [CrossRef]
- Van Rijssen, T.J.; Van Dijk, E.H.; Yzer, S.; Ohno-Matsui, K.; Keunen, J.E.; Schlingemann, R.O.; Sivaprasad, S.; Querques, G.; Downes, S.M.; Fauser, S.; et al. Central serous chorioretinopathy: Towards an evidence-based treatment guideline. Prog. Retin. Eye Res. 2019, 73, 100770. [Google Scholar] [CrossRef]
- Ambiya, V.; Khodani, M.; Goud, A.; Narayanan, R.; Tyagi, M.; Rani, P.K.; Chhablani, J. Early Focal Laser Photocoagulation in Acute Central Serous Chorioretinopathy: A Prospective, Randomized Study. Ophthalmic Surg. Lasers Imaging Retin. 2017, 48, 564–571. [Google Scholar] [CrossRef]
- Rasheed, M.A.; Goud, A.; Mohamed, A.; Vupparaboina, K.K.; Chhablani, J. Change in choroidal vascularity in acute central serous chorioretinopathy. Indian J. Ophthalmol. 2018, 66, 530–534. [Google Scholar]
- Sartini, F.; Figus, M.; Nardi, M.; Casini, G.; Posarelli, C. Non-resolving, recurrent and chronic central serous chorioretinopathy: Available treatment options. Eye 2019, 33, 1035–1043. [Google Scholar] [CrossRef]
- Fercher, A.F.; Hitzenberger, C.K.; Drexler, W.; Kamp, G.; Sattmann, H. In vivo optical coherence tomography. Am. J. Ophthalmol. 1993, 116, 113–114. [Google Scholar] [CrossRef]
- Huang, D.; Swanson, E.A.; Lin, C.P.; Schuman, J.S.; Stinson, W.G.; Chang, W.; Hee, M.R.; Flotte, T.; Gregory, K.; Puliafito, C.; et al. Optical coherence tomography. Science 1991, 254, 1178–1181. [Google Scholar] [CrossRef]
- Hussain, M.A.; Bhuiyan, A.; Ishikawa, H.; Smith, R.T.; Schuman, J.S.; Kotagiri, R. An automated method for choroidal thickness measurement from Enhanced Depth Imaging Optical Coherence Tomography images. Comput. Med. Imaging Gr. 2018, 63, 41–51. [Google Scholar] [CrossRef] [PubMed]
- McNabb, R.P.; Grewal, D.S.; Mehta, R.; Schuman, S.G.; Izatt, J.A.; Mahmoud, T.H.; Jaffe, G.J.; Mruthyunjaya, P.; Kuo, A.N. Wide field of view swept-source optical coherence tomography for peripheral retinal disease. Br. J. Ophthalmol. 2016, 100, 1377–1382. [Google Scholar] [CrossRef]
- Spaide, R.F.; Koizumi, H.; Pozzoni, M.C. Enhanced depth imaging spectral-domain optical coherence tomography. Am. J. Ophthalmol. 2008, 146, 496–500. [Google Scholar] [CrossRef] [PubMed]
- Waldstein, S.M.; Faatz, H.; Szimacsek, M.; Glodan, A.-M.; Podkowinski, D.; Montuoro, A.; Simader, C.; Gerendas, B.S.; Schmidt, W.M. Comparison of penetration depth in choroidal imaging using swept source vs spectral domain optical coherence tomography. Eye 2015, 29, 409–415. [Google Scholar] [CrossRef]
- Kolb, J.P.; Klein, T.; Kufner, C.L.; Wieser, W.; Neubauer, A.S.; Huber, R. Ultra-widefield retinal MHz-OCT imaging with up to 100 degrees viewing angle. Biomed Opt. Express 2015, 6, 1534–1552. [Google Scholar] [CrossRef] [PubMed]
- Rasheed, M.A.; Singh, S.R.; Invernizzi, A.; Cagini, C.; Goud, A.; Sahoo, N.K.; Cozzi, M.; Lupidi, M.; Chhablani, J. Wide-field choroidal thickness profile in healthy eyes. Sci. Rep. 2018, 8, 17166. [Google Scholar] [CrossRef]
- Mohler, K.J.; Draxinger, W.; Klein, T.; Kolb, J.P.; Wieser, W.; Haritoglou, C.; Kampik, A.; Fujimoto, J.G.; Neubauer, A.S.; Huber, R.; et al. Combined 60 degrees Wide-Field Choroidal Thickness Maps and High-Definition En Face Vasculature Visualization Using Swept-Source Megahertz OCT at 1050 nm. Investig. Ophthalmol. Vis. Sci. 2015, 56, 6284–6293. [Google Scholar] [CrossRef]
- Carrai, P.; Pichi, F.; Bonsignore, F.; Ciardella, A.P.; Nucci, P. Wide-field spectral domain-optical coherence tomography in central serous chorioretinopathy. Int. Ophthalmol. 2015, 35, 167–171. [Google Scholar] [CrossRef]
- Singh, S.R.; Invernizzi, A.; Rasheed, M.A.; Cagini, C.; Goud, A.; Vupparaboina, K.K.; Cozzi, M.; Lupidi, M.; Chhablani, J. Wide-field Choroidal Vascularity in Healthy Eyes. Am. J. Ophthalmol. 2018, 193, 100–105. [Google Scholar] [CrossRef] [PubMed]
- Lau, T.; Wong, I.Y.; Iu, L.; Yong, T.; Lee, J.W.; Wong, R.; Chhablani, J.; Hideki, K. En-face optical coherence tomography in the diagnosis and management of age-related macular degeneration and polypoidal choroidal vasculopathy. Indian J. Ophthalmol. 2015, 63, 378–383. [Google Scholar] [PubMed]
- Mavrommatis, M.A.; De Cuir, N.; Reynaud, J.; De Moraes, C.G.; Xin, D.; Rajshekhar, R.; Liebmann, J.M.; Ritch, R.; Fortune, B.; Hood, D.C. An Examination of the Frequency of Paravascular Defects and Epiretinal Membranes in Eyes With Early Glaucoma Using En-face Slab OCT Images. J. Glaucoma 2019, 28, 265–269. [Google Scholar] [CrossRef] [PubMed]
- Ferrara, D.; Mohler, K.J.; Waheed, N.; Adhi, M.; Liu, J.J.; Grulkowski, I.; Kraus, M.F.; Baumal, C.; Hornegger, J.; Fujimoto, J.G.; et al. En Face Enhanced-Depth Swept-Source Optical Coherence Tomography Features of Chronic Central Serous Chorioretinopathy. Ophthalmology 2014, 121, 719–726. [Google Scholar] [CrossRef]
- Vupparaboina, K.K.; Nizampatnam, S.; Chhablani, J.; Richhariya, A.; Jana, S. Automated estimation of choroidal thickness distribution and volume based on OCT images of posterior visual section. Comput. Med. Imaging Gr. 2015, 46, 315–327. [Google Scholar] [CrossRef]
- Wong, R.L.; Singh, S.R.; Rasheed, M.A.; Goud, A.; Chhablani, G.; Samantaray, S.; AnkiReddy, S.; Vupparaboina, K.K.; Chhablani, J. En-face choroidal vascularity in central serous chorioretinopathy. Eur. J. Ophthalmol. 2020, 2020. [Google Scholar] [CrossRef]
- Savastano, M.C.; Rispoli, M.; Savastano, A.; Lumbroso, B. En Face Optical Coherence Tomography for Visualization of the Choroid. Ophthalmic Surg. Lasers Imaging Retin. 2015, 46, 561–565. [Google Scholar] [CrossRef]
- Savastano, M.C.; Dansingani, K.K.; Rispoli, M.; Virgili, G.; Savastano, A.; Freund, K.B.; Lumbroso, B. Classification of Haller Vessel Arrangements in Acute and Chronic Central Serous Chorioretinopathy Imaged with En Face Optical Coherence Tomography. Retina 2018, 38, 1211–1215. [Google Scholar] [CrossRef]
- Eom, Y.; Oh, J.; Kim, S.W.; Huh, K. Systemic factors associated with central serous chorioretinopathy in Koreans. Korean J. Ophthalmol. 2012, 26, 260–264. [Google Scholar] [CrossRef]
- Piccolino, F.C.; Lupidi, M.; Cagini, C.; Fruttini, D.; Nicolò, M.; Eandi, C.M.; Tito, S. Choroidal Vascular Reactivity in Central Serous Chorioretinopathy. Investig. Opthalmol. Vis. Sci. 2018, 59, 3897–3905. [Google Scholar] [CrossRef]
- Tittl, M.K.; Spaide, R.F.; Wong, D.; Pilotto, E.; Yannuzzi, L.A.; Fisher, Y.L.; Freund, B.; Guyer, D.R.; Slakter, J.S.; Sorenson, J.A. Systemic findings associated with central serous chorioretinopathy. Am. J. Ophthalmol. 1999, 128, 63–68. [Google Scholar] [CrossRef]
- Hietanen, E. Cardiovascular responses to static exercise. Scand. J. Work Environ. Health 1984, 10, 397–402. [Google Scholar] [CrossRef] [PubMed]
- Nickla, D.L.; Wallman, J. The multifunctional choroid. Prog. Retin. Eye Res. 2010, 29, 144–168. [Google Scholar] [CrossRef] [PubMed]
- May, C.A. Non-vascular smooth muscle cells in the human choroid: Distribution, development and further characterization. J. Anat. 2005, 207, 381–390. [Google Scholar] [CrossRef] [PubMed]
- Hiroe, T.; Kishi, S. Dilatation of Asymmetric Vortex Vein in Central Serous Chorioretinopathy. Ophthalmol Retin. 2018, 2, 152–161. [Google Scholar] [CrossRef] [PubMed]
- Matet, A.; Daruich, A.; Hardy, S.; Behar-Cohen, F. Patterns of Choriocapillaris Flow Signal Voids in Central Serous Chorioretinopathy: An Optical Coherence Tomography Angiography Study. Retina 2019, 39, 2178–2188. [Google Scholar] [CrossRef] [PubMed]
- Yun, C.; Huh, J.; Ahn, S.M.; Lee, B.; Kim, J.T.; Hwang, S.-Y.; Kim, S.-W.; Oh, J.R. Choriocapillaris flow features and choroidal vasculature in the fellow eyes of patients with acute central serous chorioretinopathy. Graefes Arch. Clin. Exp. Ophthalmol. 2019, 257, 57–70. [Google Scholar] [CrossRef]
- Baek, J.; Kook, L.; Lee, W.K. Choriocapillaris Flow Impairments in Association with Pachyvessel in Early Stages of Pachychoroid. Sci. Rep. 2019, 9, 5565. [Google Scholar] [CrossRef]
- Bousquet, E.; Bonnin, S.; Mrejen, S.; Krivosic, V.; Tadayoni, R.; Gaudric, A. Optical Coherence Tomography Angiography of Flat Irregular Pigment Epithelium Detachment in Chronic Central Serous Chorioretinopathy. Retina 2018, 38, 629–638. [Google Scholar] [CrossRef]
- Costanzo, E.; Cohen, S.Y.; Miere, A.; Querques, G.; Capuano, V.; Semoun, O.; El Ameen, A.; Oubraham, H.; Souied, E. Optical Coherence Tomography Angiography in Central Serous Chorioretinopathy. J. Ophthalmol. 2015, 2015, 134783. [Google Scholar] [CrossRef]
- Cakir, B.; Reich, M.; Lang, S.; Bühler, A.; Ehlken, C.; Grundel, B.; Stech, M.; Reichl, S.; Stahl, A.; Böhringer, D.; et al. OCT Angiography of the Choriocapillaris in Central Serous Chorioretinopathy: A Quantitative Subgroup Analysis. Ophthalmol. Ther. 2019, 8, 75–86. [Google Scholar] [CrossRef] [PubMed]
- Hanumunthadu, D.; Matet, A.; Rasheed, M.A.; Goud, A.; Vuppurabina, K.K.; Chhablani, J. Evaluation of choroidal hyperreflective dots in acute and chronic central serous chorioretinopathy. Indian J. Ophthalmol. 2019, 67, 1850–1854. [Google Scholar] [PubMed]
- Uppugunduri, S.R.; Rasheed, M.A.; Richhariya, A.; Jana, S.; Chhablani, J.; Vupparaboina, K.K. Automated quantification of Haller’s layer in choroid using swept-source optical coherence tomography. PLoS ONE 2018, 13, e0193324. [Google Scholar] [CrossRef] [PubMed]
- Jung, H.; Liu, T.; Liu, J.; Huryn, L.A.; Tam, J. Combining multimodal adaptive optics imaging and angiography improves visualization of human eyes with cellular-level resolution. Commun. Biol. 2018, 1, 189. [Google Scholar] [CrossRef] [PubMed]
- Puyo, L.; Paques, M.; Fink, M.; Sahel, J.A.; Atlan, M. Waveform analysis of human retinal and choroidal blood flow with laser Doppler holography. Biomed. Opt. Express 2019, 10, 4942–4963. [Google Scholar] [CrossRef]
- Puyo, L.; Paques, M.; Fink, M.; Sahel, J.A.; Atlan, M. Choroidal vasculature imaging with laser Doppler holography. Biomed. Opt. Express 2019, 10, 995–1012. [Google Scholar] [CrossRef] [PubMed]

Publisher’s Note: MDPI stays neutral with regard to jurisdictional claims in published maps and institutional affiliations. |
© 2020 by the authors. Licensee MDPI, Basel, Switzerland. This article is an open access article distributed under the terms and conditions of the Creative Commons Attribution (CC BY) license (http://creativecommons.org/licenses/by/4.0/).
Share and Cite
Nkrumah, G.; Maltsev, D.S.; Manuel, P.-E.A.; Rasheed, M.A.; Cozzi, M.; Ivernizzi, A.; Lupidi, M.; Singh, S.R.; Chhablani, J. Current Choroidal Imaging Findings in Central Serous Chorioretinopathy. Vision 2020, 4, 44. https://doi.org/10.3390/vision4040044
Nkrumah G, Maltsev DS, Manuel P-EA, Rasheed MA, Cozzi M, Ivernizzi A, Lupidi M, Singh SR, Chhablani J. Current Choroidal Imaging Findings in Central Serous Chorioretinopathy. Vision. 2020; 4(4):44. https://doi.org/10.3390/vision4040044
Chicago/Turabian StyleNkrumah, Gideon, Dmitrii S. Maltsev, Paez-Escamilla A. Manuel, Mohammed A. Rasheed, Marianno Cozzi, Alessandro Ivernizzi, Marco Lupidi, Sumit Randhir Singh, and Jay Chhablani. 2020. "Current Choroidal Imaging Findings in Central Serous Chorioretinopathy" Vision 4, no. 4: 44. https://doi.org/10.3390/vision4040044
APA StyleNkrumah, G., Maltsev, D. S., Manuel, P.-E. A., Rasheed, M. A., Cozzi, M., Ivernizzi, A., Lupidi, M., Singh, S. R., & Chhablani, J. (2020). Current Choroidal Imaging Findings in Central Serous Chorioretinopathy. Vision, 4(4), 44. https://doi.org/10.3390/vision4040044

